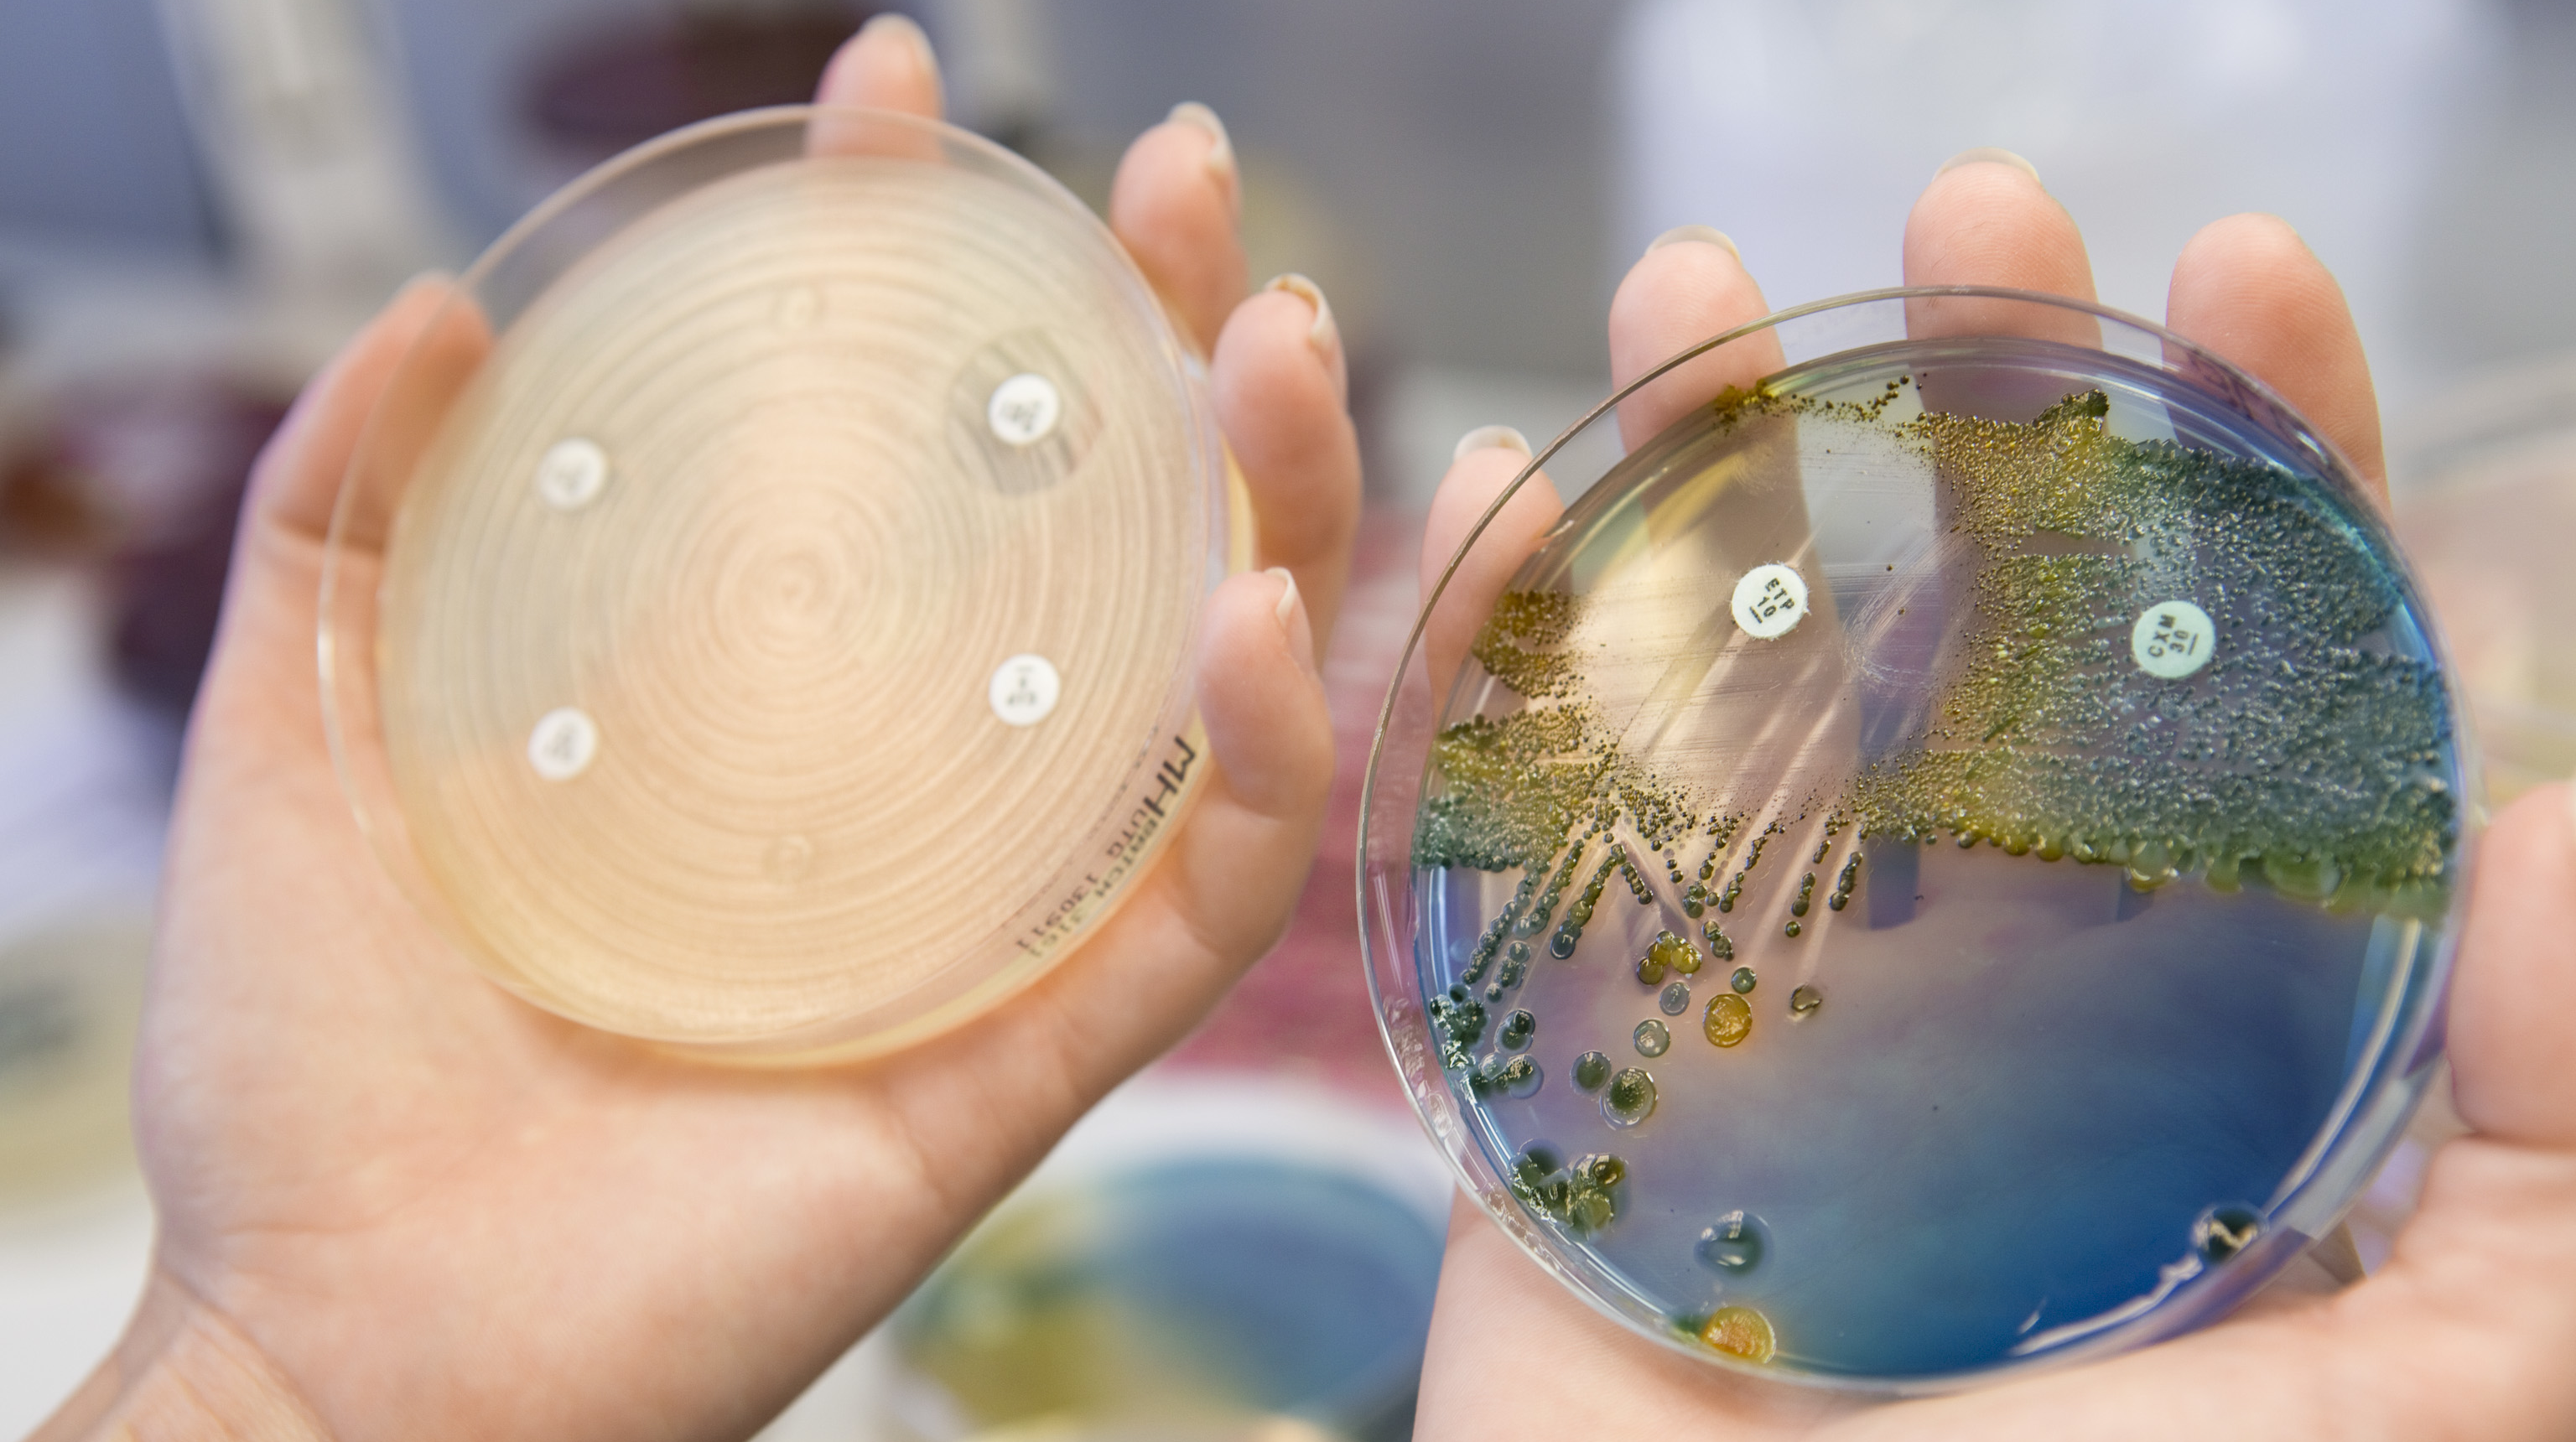

Startsida för ALF
Senaste nytt
-
 Trevlig sommar önskar vi på ALF-kontoret
Trevlig sommar önskar vi på ALF-kontoretVi hoppas att ni får en avkopplande sommar med tid för återhämtning, reflektion och inspiration.
-
 ALF-medel för samverkan inom primär- och slutenvårdsforskning 2027–2028
ALF-medel för samverkan inom primär- och slutenvårdsforskning 2027–2028Under perioden 15 oktober–7 december 2026 utlyses särskilda ALF‑medel för forskningsprojekt som bedrivs i samverkan mellan primärvård och slutenvård inom Västra Götalandsregionen (VGR).
-
 Presentation från informationsmötet finns nu publicerad
Presentation från informationsmötet finns nu publiceradHär kan du ta del av presentationen från det digitala informationsmötet som hölls måndag 13 april och som ger en översikt av vårens ALF‑utlysningar 2026.
-
 Välkommen till digitalt informationsmöte om vårens ALF-utlysningar
Välkommen till digitalt informationsmöte om vårens ALF-utlysningarCaterina Finizia, FoUUI-direktör vid Sahlgrenska Universitetssjukhuset, Magnus Simrén, prodekan vid Sahlgrenska akademin, Göteborgs universitet, och Kristina Eriksson, ALF-strateg, håller ett digitalt informationsmöte om vårens ALF-utlysningar.